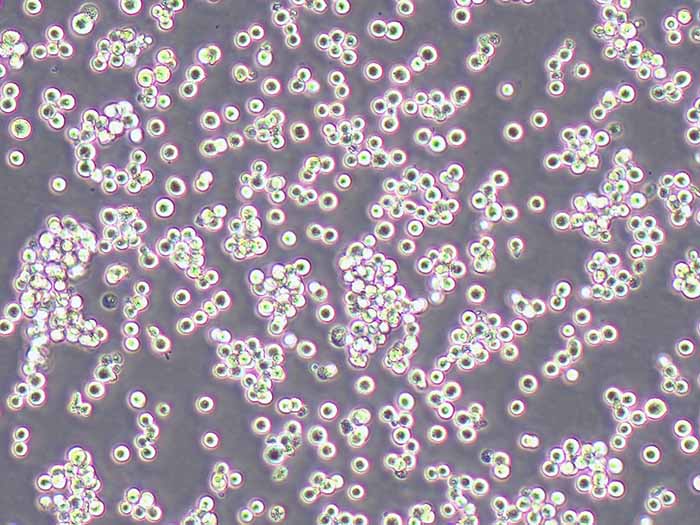
LLC-WRC 256大鼠腹水癌细胞

ZR-75-1人乳腺癌细胞(STR鉴定正确)
¥1200元

人软骨细胞(永生化)
¥2500元
LLC-WRC 256大鼠腹水癌细胞
¥2500元

BRL-3A大鼠肝细胞
¥1200元

HSC-T6大鼠肝星形细胞
¥1200元

CFSC-8B大鼠肝星形细胞
¥1200元

NR8383大鼠肺泡巨噬细胞
¥1500元

IEC-6大鼠小肠隐窝上皮细胞
¥1200元

NRK-52E大鼠肾细胞(种属鉴定)
¥1500元

RIN-M5F大鼠胰岛β细胞瘤细胞
¥1200元

PC-12大鼠肾上腺嗜铬细胞瘤细胞(未分化)
¥1200元

AR42J大鼠胰腺外分泌细胞
¥1200元

CTX-TNA2大鼠脑I型星形胶质细胞
¥1200元

C6大鼠脑胶质瘤细胞
¥1200元

GH3大鼠垂体瘤细胞
¥1200元

A7R5大鼠胸大动脉平滑肌细胞
¥1200元

INS-1大鼠胰岛细胞瘤细胞(种属鉴定正确)
¥1500元

MADB106大鼠乳腺癌细胞
¥1800元